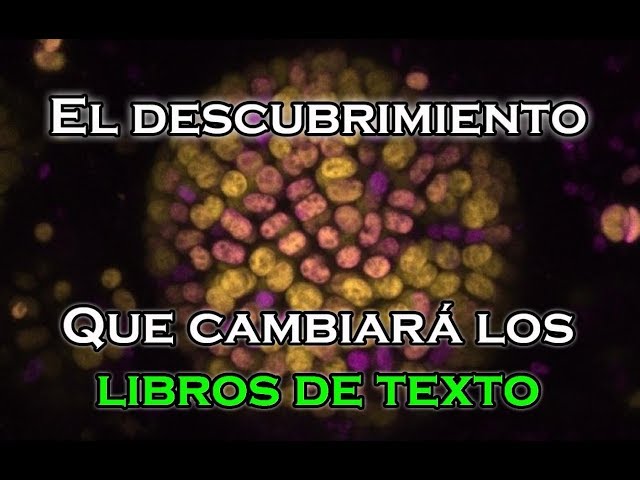
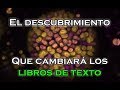

Científicos de varias universidades han descubierto una nueva fotosíntesis; algo que cambiará los libros de texto. También adaptará la forma en que buscamos vida extraterrestre y brindará información sobre cómo podríamos diseñar cultivos más eficientes que aprovechen las longitudes de onda de luz más largas…
►Suscríbete a Atraviesa lo desconocido: http://goo.gl/JHK2X7
►Mi canal de noticias: http://goo.gl/KSJwUN
►Mi canal secundario: http://goo.gl/aIn6AY
►Mi Web: http://atraviesalodesconocido.blogspo...
★↓Sígueme en mis redes sociales↓★
Facebook: https://www.facebook.com/Atraviesalod...
Twitter: https://twitter.com/AtraviesaLoDesc
Dailymotion: http://www.dailymotion.com/Atraviesal...
★Mi libro "Nuestro origen extraterrestre"★
Amazon: http://goo.gl/Adzf69
Planetadelibros: http://goo.gl/WHXpdM
Foto de portada: Dennis Nuernberg / Colegio Imperial de Londres
Estudio:
http://science.sciencemag.org/content...
Descubren Algo Increíble que Cambiará los Libros de Ciencia ─ Atraviesa lo desconocido
<style>.embed-container { position: relative; padding-bottom: 56.25%; height: 0; overflow: hidden; max-width: 100%; } .embed-container iframe, .embed-container object, .embed-container embed { position: absolute; top: 0; left: 0; width: 100%; height: 100%; }</style><div class="embed-container"><iframe src="https://www.youtube.com/embed/yqCsxmOWDF0" frameborder="0" allowfullscreen></iframe></div>